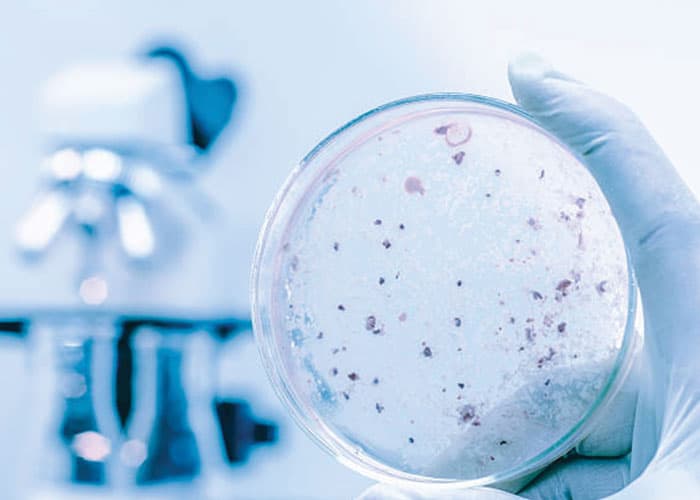

Légionellose et canalisations : comment éviter la prolifération bactérienne ?
Chaque année, plusieurs centaines de cas de légionellose sont recensés en France. Derrière ce nom scientifique se cache une maladie respiratoire sévère provoquée par la bactérie Legionella pneumophila, qui adore se développer dans l’eau tiède des réseaux sanitaires.
Un réseau de canalisations mal entretenu devient ainsi un véritable terrain de jeu pour cette bactérie. La bonne nouvelle ? La prévention est possible, et des solutions innovantes comme le procédé ACQUAPROCESS® apportent aujourd’hui une réponse efficace et durable.
Légionellose : une menace silencieuse
La légionellose est une infection pulmonaire comparable à une pneumonie aiguë. Elle se contracte en inhalant de minuscules gouttelettes d’eau contaminées : douches, tours de refroidissement, jacuzzis, robinets ou tout système produisant des aérosols.
Population à risque : personnes âgées, immunodéprimées, fumeurs ou malades chroniques.
Conséquences : fièvre élevée, toux, difficultés respiratoires, parfois graves.
En France, la réglementation impose une surveillance stricte des réseaux collectifs : analyse régulière de l’eau, maintien des températures, entretien des installations. Mais ces obligations, bien que nécessaires, ne suffisent pas toujours si l’infrastructure présente des faiblesses structurelles ou un suivi irrégulier.
Pourquoi les canalisations favorisent la prolifération
La bactérie Legionella se développe idéalement entre 25 °C et 45 °C, précisément la plage de température de nombreux réseaux d’eau chaude sanitaire. Plusieurs facteurs aggravent la situation :
- Stagnation de l’eau : sections de tuyaux peu utilisées, bras morts, réservoirs insuffisamment purgés.
- Biofilm : ce dépôt visqueux formé de micro-organismes se fixe sur les parois et protège la bactérie.
- Tartre et corrosion : ils créent des niches qui favorisent la colonisation bactérienne.
Résultat : même un réseau conforme aux normes peut, au fil du temps, devenir un incubateur si la maintenance n’est pas proactive.
Les bonnes pratiques préventives
Pour limiter la prolifération, plusieurs gestes sont incontournables :
- Maintenir les bonnes températures : eau chaude stockée à ≥ 60 °C et distribuée à ≥ 50 °C, eau froide < 20 °C.
- Éliminer les zones de stagnation : purger régulièrement les points peu utilisés, supprimer les « bras morts ».
- Nettoyer et détartrer : un détartrage annuel des ballons et un brossage des surfaces critiques réduisent le biofilm.
- Contrôler et tracer : analyses microbiologiques régulières, carnet sanitaire à jour.
Ces actions constituent la base. Mais dans les réseaux complexes (hôpitaux, hôtels, résidences, sites industriels), elles peuvent se révéler insuffisantes. C’est là qu’intervient ACQUAPROCESS®.
ACQUAPROCESS® : une technologie brevetée au service de la qualité de l’eau
Principe général
ACQUAPROCESS® est un procédé innovant de traitement de l’eau conçu pour agir en continu sur les réseaux de canalisations. Son objectif : supprimer le biofilm et maintenir une qualité microbiologique optimale, tout en respectant les réglementations en vigueur.
Atouts majeurs
- Action préventive et curative : il agit à la fois sur la contamination existante et empêche la reformation du biofilm.
- Technologie respectueuse de l’environnement : faible impact chimique, pas de rejet toxique, conformité REACH.
- Durabilité : une efficacité mesurable sur la durée, avec un suivi en temps réel.
Contrairement aux désinfections ponctuelles au chlore ou à l’hyperchlorination, ACQUAPROCESS® n’expose ni les utilisateurs ni les canalisations à des doses agressives. Il s’intègre au fonctionnement normal du réseau.
Comment se déroule une mise en œuvre ACQUAPROCESS®
La réussite du traitement passe par une méthodologie stricte :
- Audit du réseau – Des spécialistes agréés analysent la configuration : températures, débits, points de stagnation, qualité de l’eau.
- Installation – Les modules ACQUAPROCESS® sont intégrés au système, sans interruption majeure d’activité.
- Suivi continu – Des capteurs et un reporting régulier garantissent l’efficacité : baisse de la charge bactérienne, disparition progressive du biofilm.
- Maintenance planifiée – Des contrôles périodiques assurent la conformité légale et la performance à long terme.
Ce suivi « clé en main » permet aux établissements de se concentrer sur leur cœur de métier tout en ayant l’assurance d’un réseau sûr.
Bénéfices sanitaires et économiques
Investir dans ACQUAPROCESS® offre un double avantage :
- Sanitaire : réduction drastique du risque de légionellose, protection des usagers, conformité réglementaire.
- Économique : moins d’interventions d’urgence, pas de fermetures forcées, durée de vie prolongée des installations, baisse des coûts d’énergie grâce à un réseau propre.
De nombreux hôpitaux, résidences collectives, hôtels ou sites industriels constatent un retour sur investissement rapide : un réseau sain consomme moins d’énergie et nécessite moins de réparations.
Études de cas et retours d’expérience
Dans plusieurs établissements de santé, le procédé ACQUAPROCESS® a permis :
- Une réduction de plus de 90 % de la concentration de Legionella en quelques semaines.
- La stabilisation durable des paramètres d’eau, réduisant les besoins en désinfection choc.
- Une meilleure satisfaction des inspections sanitaires, gage de confiance auprès des patients et des autorités.
Ces résultats démontrent que la prévention n’est pas seulement une obligation, mais une stratégie rentable.
Vers une gestion intelligente de l’eau
Le traitement de l’eau évolue vers des solutions connectées. ACQUAPROCESS® s’inscrit déjà dans cette tendance :
- Monitoring en temps réel via capteurs IoT.
- Alertes automatiques en cas de dérive de température ou de concentration bactérienne.
- Intégration possible avec les systèmes de gestion technique des bâtiments (GTB).
Cette approche prédictive anticipe les problèmes avant qu’ils ne surviennent.
La prévention, un investissement vital
La légionellose n’est pas une fatalité. Un réseau bien conçu, entretenu et surveillé limite déjà le risque. Mais pour les installations complexes ou sensibles, le procédé ACQUAPROCESS® constitue une réponse de pointe : il agit en continu, respecte l’environnement et assure une sécurité sanitaire durable.
Que vous soyez gestionnaire d’un hôtel, responsable technique d’un hôpital ou exploitant d’un immeuble collectif, investir dans un traitement innovant est bien plus qu’une dépense : c’est une garantie de sérénité, de conformité et de protection pour tous les usagers.